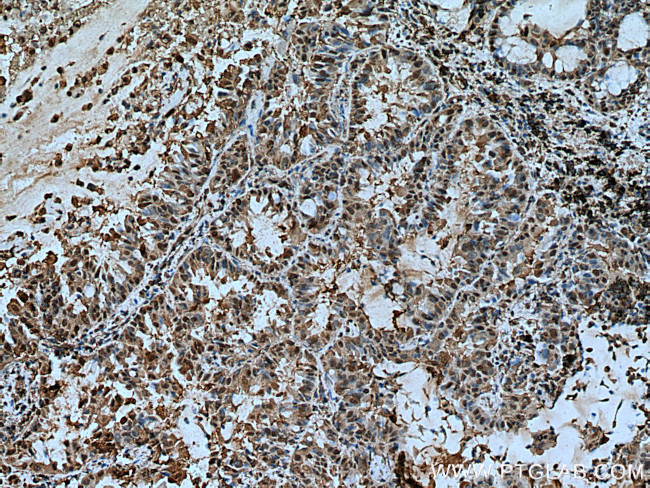
YWHAZ Antibody in Immunohistochemistry (Paraffin) (IHC (P))

Search
Proteintech
YWHAZ Monoclonal Antibody (3G12B10)
{{$productOrderCtrl.translations['antibody.pdp.commerceCard.promotion.promotions']}}
{{$productOrderCtrl.translations['antibody.pdp.commerceCard.promotion.viewpromo']}}
{{$productOrderCtrl.translations['antibody.pdp.commerceCard.promotion.promocode']}}: {{promo.promoCode}} {{promo.promoTitle}} {{promo.promoDescription}}. {{$productOrderCtrl.translations['antibody.pdp.commerceCard.promotion.learnmore']}}
产品信息
67698-1-IG
种属反应
宿主/亚型
分类
类型
克隆号
抗原
偶联物
形式
浓度
规格
纯化类型
保存液
内含物
保存条件
运输条件
产品详细信息
Aliquoting is unnecessary for -20°C storage.
靶标信息
At least seven isoforms comprise the highly conserved 14-3-3 family of homo- and heterodimeric proteins that are abundantly expressed in all eukaryotic cells. Although more than seven isoforms of 14-3-3 have been described, some redundancies have appeared upon sequencing. The 14-3-3s are thought to be key regulators of signal transduction events mediated through their binding to serine-phosphorylated proteins. By interacting with Cdc25C, 14-3-3 regulates entry into the cell cycle and through interaction with Bad, prevents apoptosis. Other proteins that have been shown to bind to 14-3-3s include members of the protein kinase C family, Cbl, IRS-1, polyoma middle-T antigen, nitrate reductase, S-raf and the IGF-1 receptor. Detection of 14-3-3 proteins in cerebrospinal fluid has been shown to be useful in the differential diagnosis of Creutzfeldt-Jakob disease and other prion diseases.
仅用于科研。不用于诊断过程。未经明确授权不得转售。
篇参考文献 (0)
生物信息学
蛋白别名: 14-3-3 delta; 14-3-3 protein zeta/delta; 14-3-3 protein/cytosolic phospholipase A2; 14-3-3 zeta; 1433Z; 143Z; epididymis luminal protein 4; epididymis secretory protein Li 3; epididymis secretory protein Li 93; KCIP-1; Mitochondrial import stimulation factor S1 subunit; phospholipase A2; Protein kinase C inhibitor protein 1; protein kinase C inhibitor protein-1; SEZ-2; tyrosine 3-monooxygenase/tryptophan 5-monooxygenase activation protein, delta polypeptide; tyrosine 3-monooxygenase/tryptophan 5-monooxygenase activation protein, zeta polypeptide; tyrosine 3/tryptophan 5 -monooxygenase activation protein, zeta polypeptide; unnamed protein product
基因别名: 1110013I11Rik; 14-3-3-zeta; 14-3-3z; 14-3-3zeta; AI596267; AL022924; AU020854; HEL-S-3; HEL-S-93; HEL4; KCIP-1; Msfs1; POPCHAS; YWHAD; YWHAZ
UniProt ID: (Human) P63104, (Mouse) P63101, (Rat) P63102
Entrez Gene ID: (Human) 7534, (Mouse) 22631, (Rat) 25578